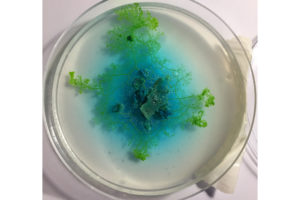
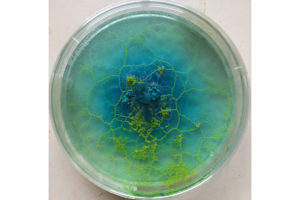
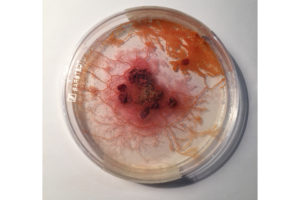

SLIMOCRACY
Slimocracy ist ein spekulatives Szenario, bei dem ein intelligentes Lebewesen im Mittelpunkt steht und Entscheidungen auf Basis von seinem Verhalten getroffen werden. Der Schleimpilz ist in der Lage, den kürzesten Weg zwischen zwei Futterquellen (Haferflocken) zu finden und sich diesen zu merken. Diese Eigenschaft wird auf das foodsharing System angewendet. Rote Haferflocken stehen für einen Überschuss an Nahrung (Betriebe, die Lebensmittel übrig haben). Blaue Haferflocken stehen für einen Mangel (Foodsaver, die Lebensmittel abholen). Foodsharing funktioniert durch lokale Zusammenarbeit. In den jeweiligen Bezirken arbeiten Betriebe und Foodsaver zusammen daran, Lebensmittel vor dem Wegwerfen zu bewahren. Der Schleimpilz bietet eine Visualisierung der verschiedenen Teilnehmer und der kürzesten Strecke zwischen ihnen. Über die Slime Mold Cam bekommt man alle zehn Minuten ein Update vom Wachstum des schleimigen gelben Lebewesens. Teilnehmer sollen beobachten, wie sich der Schleimpilz verhält und dann entscheiden, welche Betriebe günstig für eine Abholung gelegen sind.
Slimocracy is a speculative scenario. An intelligent slime mold is the centre of this project. The actions of people depend on the development of this intelligent Organism. The Slime mold is able to find the shortest path between two places.
This ability is applied to the foodsharing System. Red oats represent a restaurant or a supermarket so a place where is too much food. Blue Oats represent a foodsaver, someone who is willing to take the leftover food. Foodsharing is a local
cooperation. Companies and Foodsaver work together in their districts to save food before it is thrown away. The slime mold visualizes the shortest paths between the different participators. Through the slime mold cam you can observe the growth of the slime mold. The idea is that people watch the slime mold and
then decide which location is most convenient to collect leftover food.
Prozess